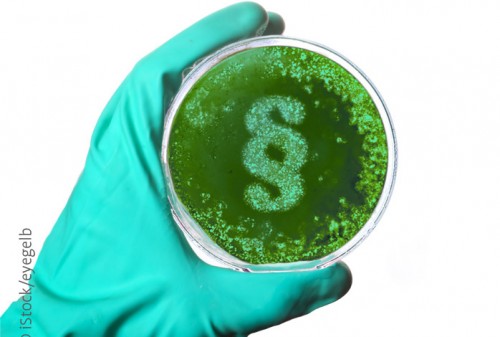

Masken als Schutzmaßnahme wurden schon im Mittelalter eingesetzt. Sie waren oft aus Leder gefertigt und dienten – neben Mänteln und Handschuhen – als Schutz für die Ärzte bei der Behandlung von Infektionskranken, z. B. Pestkranken. Teilweise waren die Masken so gestaltet, dass sie Räucherrauch abgeben konnten, oft waren sie mit Kräutern und Flüssigkeiten gefüllt – wohl in erster Linie gedacht als Schutz gegen die einwirkenden Miasmen in der Luft, die als Überträger der Infektionen angesehen wurden.
Im Operationssaal (OP) benutzte in Breslau Johann von Mikulicz-Radecki 1897 erstmals eine Maske, die aus einer Lage Mullbinde bestand. Sie hatte den Vorteil, dass sie nicht nur Mund und Nase bedeckte, sondern auch die damals (und heute wieder) üblichen Bärte.
Zeitgleich konnte Fluegge, ebenfalls in Breslau, nachweisen, dass beim Sprechen Tröpfchen mit Bakterien von Mund und Nase abgegeben werden. Schon damals wurde berichtet, dass beim Sprechen Bakterien über vier bis fünf Meter verbreitet werden können.
1898 empfahl Huebner, ebenfalls Breslau, eine Maske aus zwei Lagen Mullbinde und zeigte, dass sie effizienter war. Auch fand er, dass eine Maske nahe an der Nase feucht wurde und ihr Rückhaltevermögen abnahm. Deshalb konstruierte er ein Gestell, das den Abstand zur Nase herstellte.
In den folgenden Jahren wurde gezeigt, dass Masken den Träger schützen. 1918 berichtete Weaver, dass es zu keinen Diphtherie-Übertragungen kam, wenn von Kontaktpersonen zu Diphtheriekranken Masken getragen wurden. Capps konnte im gleichen Jahr in Militärkrankenhäusern nachweisen, dass Masken das Personal vor Infektionen schützen.
Ebenfalls 1918 berichteten Doust und Lyon, dass normales Sprechen relativ wenige Bakterien freisetzt und nur auf eine Distanz von ein bis zwei Fuß. Bei lautem Sprechen wurden mehr freigesetzt, die sich über mehr als drei Fuß ausbreiten konnten.
 1910/11 (60.000 Tote) und 1920/21 (9.300 Tote) gab es große Pestausbrüche in der Mandschurei (heute Teile Chinas, Russlands und in geringem Umfang der Mongolei). Mitarbeiter im Gesundheitswesen schützten sich mit Masken aus Baumwolle und Mullbinden. In Konsequenz war die Infektionsrate bei ihnen sehr gering.
1910/11 (60.000 Tote) und 1920/21 (9.300 Tote) gab es große Pestausbrüche in der Mandschurei (heute Teile Chinas, Russlands und in geringem Umfang der Mongolei). Mitarbeiter im Gesundheitswesen schützten sich mit Masken aus Baumwolle und Mullbinden. In Konsequenz war die Infektionsrate bei ihnen sehr gering.
1918 wurde in San Francisco während der Spanischen Grippe eine allgemeine Maskenpflicht erlassen. Allerdings wurde die Maskenpflicht zu früh aufgehoben, sodass die zweite Grippewelle die Stadt mit voller Wucht traf. Eine erneute Maskenpflicht wurde zu spät verhängt – Gründe waren u. a. die Sorge um das Weihnachtsgeschäft der Läden und die Verluste der Restaurants beim Shutdown (wen erinnert das nicht an die Corona-Pandemie…).
In den folgenden Jahren wurden die Ergebnisse bestätigt und zunehmend mehr Lagen für die Masken eingesetzt. Ende der 1920er Jahre waren Masken aus Mullbinden weit verbreitet. Engelfried und Farrer zeigten, dass eine sechs-lagige Maske die Bakterien im OP-Feld um 90 Prozent reduzieren konnte.
In den 1930er Jahren wurden zunehmend Berichte publiziert, die eine Abnahme von postoperativen Wundinfektionen – insbesondere durch Staphylococcus aureus und Streptokokken – beim Tragen von Masken durch die Operateure berichteten.
Ebenfalls in den 1930er Jahren wurden neue Masken erprobt, die zusätzlich zum Mull weitere Materialien enthielten, die in erster Linie abweisend waren. Die Zwischenlagen bestanden aus Gummi, Röntgenfilmen oder Cellulose-Baumwoll-Mischgeweben. Später kamen auch Baumwolle, Flanell und Papier zum Einsatz. Erstmals wurde ein Stück Aluminium oberhalb der Nase eingesetzt, sodass man die Maske anmodellieren konnte.
Anfang der 1940er Jahre, als Antibiotika in der Medizin eingeführt wurden, erlosch das Interesse an den Masken. Allerdings beschrieb Duguid 1946, dass beim Nießen im Mittel 39.000 Bakterien-haltige Partikel produziert wurden, 710 beim Husten und 36 beim lauten Reden. Er beschrieb auch, dass Partikel (gemeint sind Tröpfchen) unter 100 µm austrocknen und auf ein Viertel bis ein Siebtel ihrer Originalgröße schrumpfen.
Ende der 1950er Jahre wurden Masken wieder interessanter, als gleichzeitig aseptische Techniken in der Chirurgie an Bedeutung gewannen: Präoperative Hautdesinfektion, Gummihandschuhe (erstmals durch Halsted 1889), Hauben, Kittel (erstmals durch Neuber 1883) und sterile Abdeckungen. Diverse Forscher zeigten, dass die meisten Partikel aus dem Mund von Masken aufgefangen werden.
Erstmals wurden Filtermasken eingesetzt und die Kritik an zu geringer Effektivität der Mullmasken nahm zu.
1958 wurden flexible Polyvinylplastik-Masken entwickelt. 1961 wurden erstmals Filtermasken als Einmalprodukt eingesetzt. Gleichzeitig wurde darauf hingewiesen, dass die Masken an den Seiten dicht anliegen müssen.
1960 definierten Rockwood und O´Donoghue, dass Masken vom gesamten Team im OP getragen werden sollten, Mund und Nase bedecken, eine feuchte Maske entfernt werden soll, nach jeder OP eine neue Maske benutzt wird, eine Maske mit Filter bis zu drei Stunden getragen werden kann, dass Masken auf Filterbasis die besten sind – und dass während der OP Fenster und Türen geschlossen sein sollen.
1967 ermittelten Ford et al. das Rückhaltevermögen diverser Masken (u. a. Papier, Mullbinden, Nylon, Flannel, Polyester) mit 15 bis 99 Prozent, je nach Produkt.
1975 beschrieb Ritter, dass die Anzahl der Bakterien in der Luft massiv ansteigt, wenn mehrere Personen den OP betreten. 1983 berichtete Letts, dass von 5.595 beim Reden ausgestoßenen Kolonien nur eine Staphylococcus aureus war. Alle anderen waren Kommensalen, die selten Infektionen verursachen. Er empfahl wenig Konversation im OP und das Tragen von Masken. Allerdings wurden danach auch Studien (z. B. von Orrs und Chamberlain und Houang) veröffentlicht, die keinen Effekt von Masken auf die Anzahl der Wundinfektionen zeigten. Die Fallzahlen waren jedoch klein. Dazu gab es wiederum weitere Studien, die einen Effekt zeigten (z. B. von Berger). Ab den 90er Jahren wurden Masken auch zunehmend als Schutz des Personals gegenüber Blutspritzern angesehen.
In den 90er Jahren entdeckte die Medizin, dass es außerhalb von ihr ebenfalls Masken im Arbeitsschutz gab – Staubmasken, die z. B. auf Baustellen eingesetzt wurden. Bei Vergleichsuntersuchungen dieser Partikel-filtrierenden Masken vom Typ FFP1-3 (filtering facepiece) mit dem chirurgischen Mund-Nasen-Schutz (MNS) zeigte sich, dass die FFP-Masken überwiegend eine höhere Schutzwirkung hatten, vor allem, weil sie dichter saßen. Auf Grund dessen wurden in den folgenden Jahren und Jahrzehnten vermehrt FFP2- und -3-Masken auch im Gesundheitswesen eingesetzt.
Heute werden die FFP-Masken nach der Norm DIN EN 149 geprüft und der MNS nach der Norm EN 14683. Mindestrückhaltevermögen von FFP-Masken-Filtern (nicht Dichtsitz) bezüglich NaCl-Prüfaerosol:
- FFP1: 80 %
- FFP2: 94 %
- FFP3: 99 %
Beide Masken-Typen dienen sowohl dem Fremd- wie auch Eigenschutz. FFP-Masken können auch Ausatemventile haben, die zumindest das Ausatmen erleichtern. Diese können natürlich nur verwandt werden, wenn der Träger nicht infektiös ist. Bei der häufig getragenen (europäischen) FFP2-Maske entspricht die Qualität ungefähr der US-Norm N95 und in China der Norm KN95.
Die Erfahrungen mit Influenza, SARS und COVID-19 zeigen, dass die Schutzwirkung des MNS nicht wesentlich schlechter ist als die einer FFP2-Maske. FFP2-Masken werden aber unbedingt empfohlen bei Versorgung von Patienten mit Coronaviren, aviärer Influenza und Tbc. Bei MDR-Tbc muss eine FFP3-Maske getragen werden.
Im Rahmen der Schweinegrippe-Pandemie 2009 und der Coronavirus-Pandemie 2020 gab es zeitweise Mangel an MNS und FFP-Masken. Daher wurden teilweise selbst hergestellte Masken eingesetzt, überwiegend aus Textil. Das BfArM hat im Rahmen der Corona-Pandemie diese Masken als Community-Masken bezeichnet:
- Community-Maske (Behelfs-Mund-Nasen-Maske),
- medizinische Gesichtsmasken (MNS, OP-Maske),
- filtrierende Halbmasken (FFP1-3).
Selbst für Textilmasken konnte ein recht gutes Rückhaltevermögen zumindest für größere Partikel gezeigt werden (> 5 µm).
Der Hygiene-Tipp im Auftrag der DGKH gibt die Meinung der Autoren wieder.
Popp W, Jatzwauk L, Schmithausen R, Kohnen W: Hygiene-Tipp: Masken in der Medizin – eine kleine Geschichte. Passion Chirurgie. 2021 Mai; 11(05): Artikel 04_04.